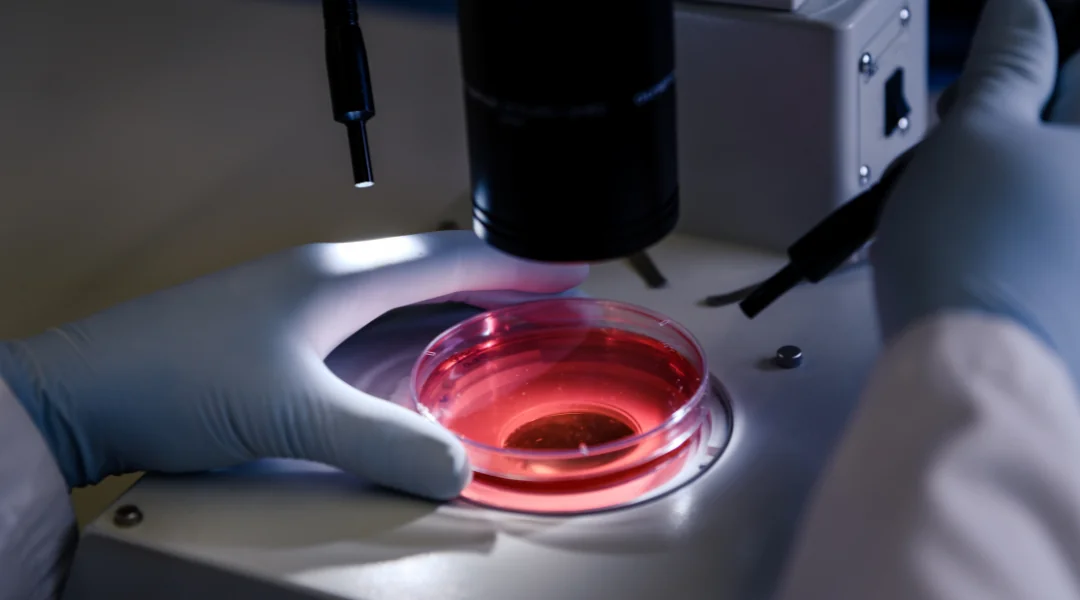
Cytology

Our Pathology Services

Hematology
Complete blood analysis to evaluate your overall health and detect various disorders.
- Complete Blood Count (CBC)
- Hemoglobin Analysis
- Coagulation Studies
- Blood Smear Examination

Clinical Chemistry
Analysis of bodily fluids to evaluate organ function and metabolic processes.
- Liver Function Tests
- Kidney Function Tests
- Lipid Profile
- Electrolyte Panel

Biochemistry
Comprehensive biochemical analysis to evaluate metabolic functions and organ health.
- Liver Function Tests
- Kidney Function Tests
- Lipid Profile
- Electrolyte Panel
- Diabetes Monitoring

Histopathology
Microscopic examination of tissues for accurate diagnosis of diseases.
- Biopsy Examination
- Cancer Diagnosis
- Special Stains
- Frozen Sections
- Immunohistochemistry
Cytology
Examination of cells for early detection of abnormalities and diseases.
- Pap Smear Tests
- Fine Needle Aspiration
- Body Fluid Analysis
- Urine Cytology
- Bronchial Washings